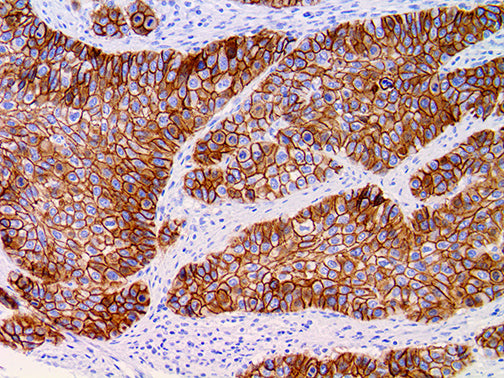
Desmoglein-3 – RMab
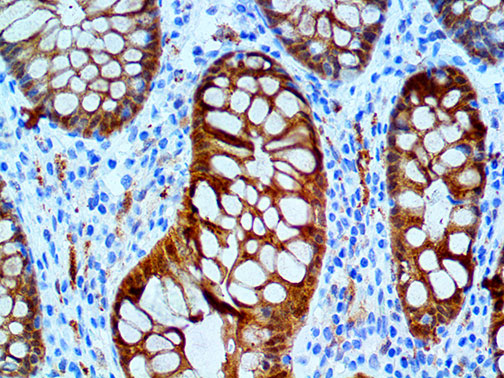
Galectin-3–MMab

COX-2 – RMab
Sale priceFrom $221.00
| COX-2 is a rabbit monoclonal antibody derived from cell culture supernatant that is concentrated, dialyzed, filter sterilized and diluted in buffer pH 7.5, containing BSA and sodium azide as a preservative. |
Cytokeratin HMW 34BetaE12 – MMab
Sale priceFrom $152.00
| Cytokeratin 34βE12 is a mouse monoclonal antibody derived from cell culture supernatant that is concentrated, dialyzed, filter sterilized and diluted in buffer pH 7.5, containing BSA and sodium azide as a preservative. |
DAB Away Kit, 500mL
Sale price$276.00
Desmin – MMab
Sale priceFrom $135.00
| Desmin antibody is a mouse monoclonal antibody derived from cell culture supernatant that is concentrated, dialyzed, filter sterilized and diluted in buffer pH 7.5, containing BSA and sodium azide as a preservative. |
EGFR – MMab
Sale priceFrom $179.00